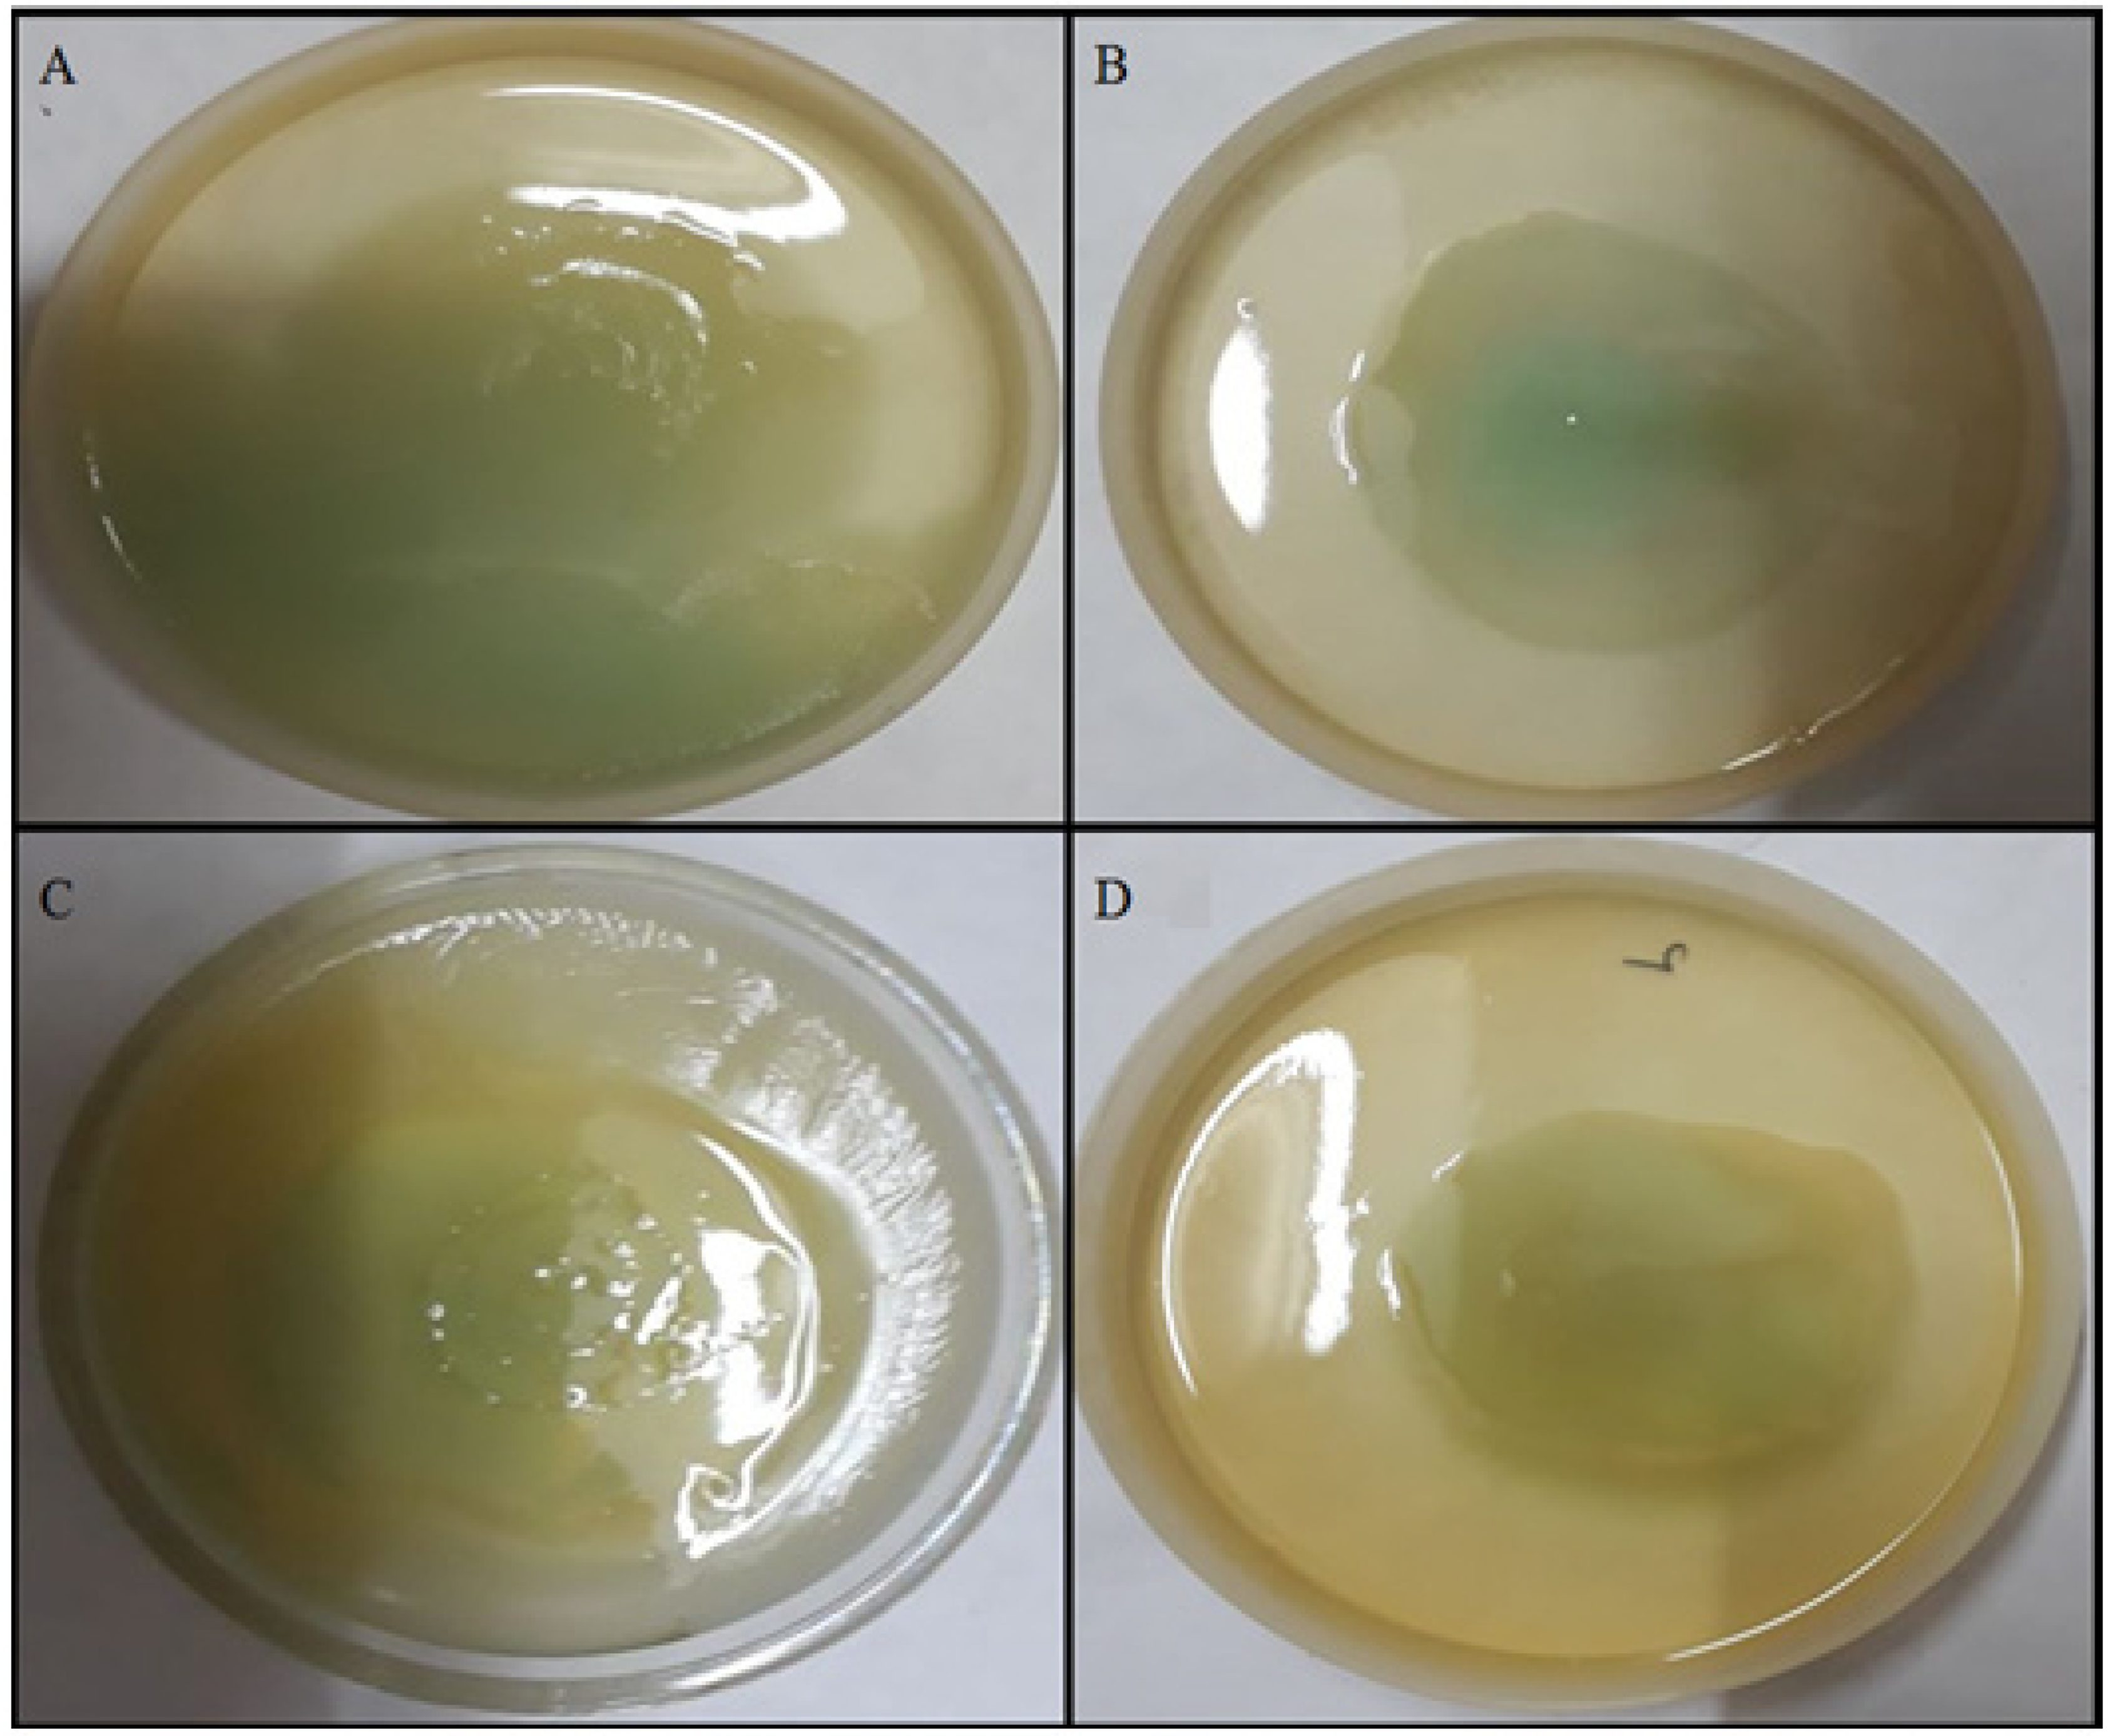
Molecules 27 08685 g009 Molecules 27 08685 g009
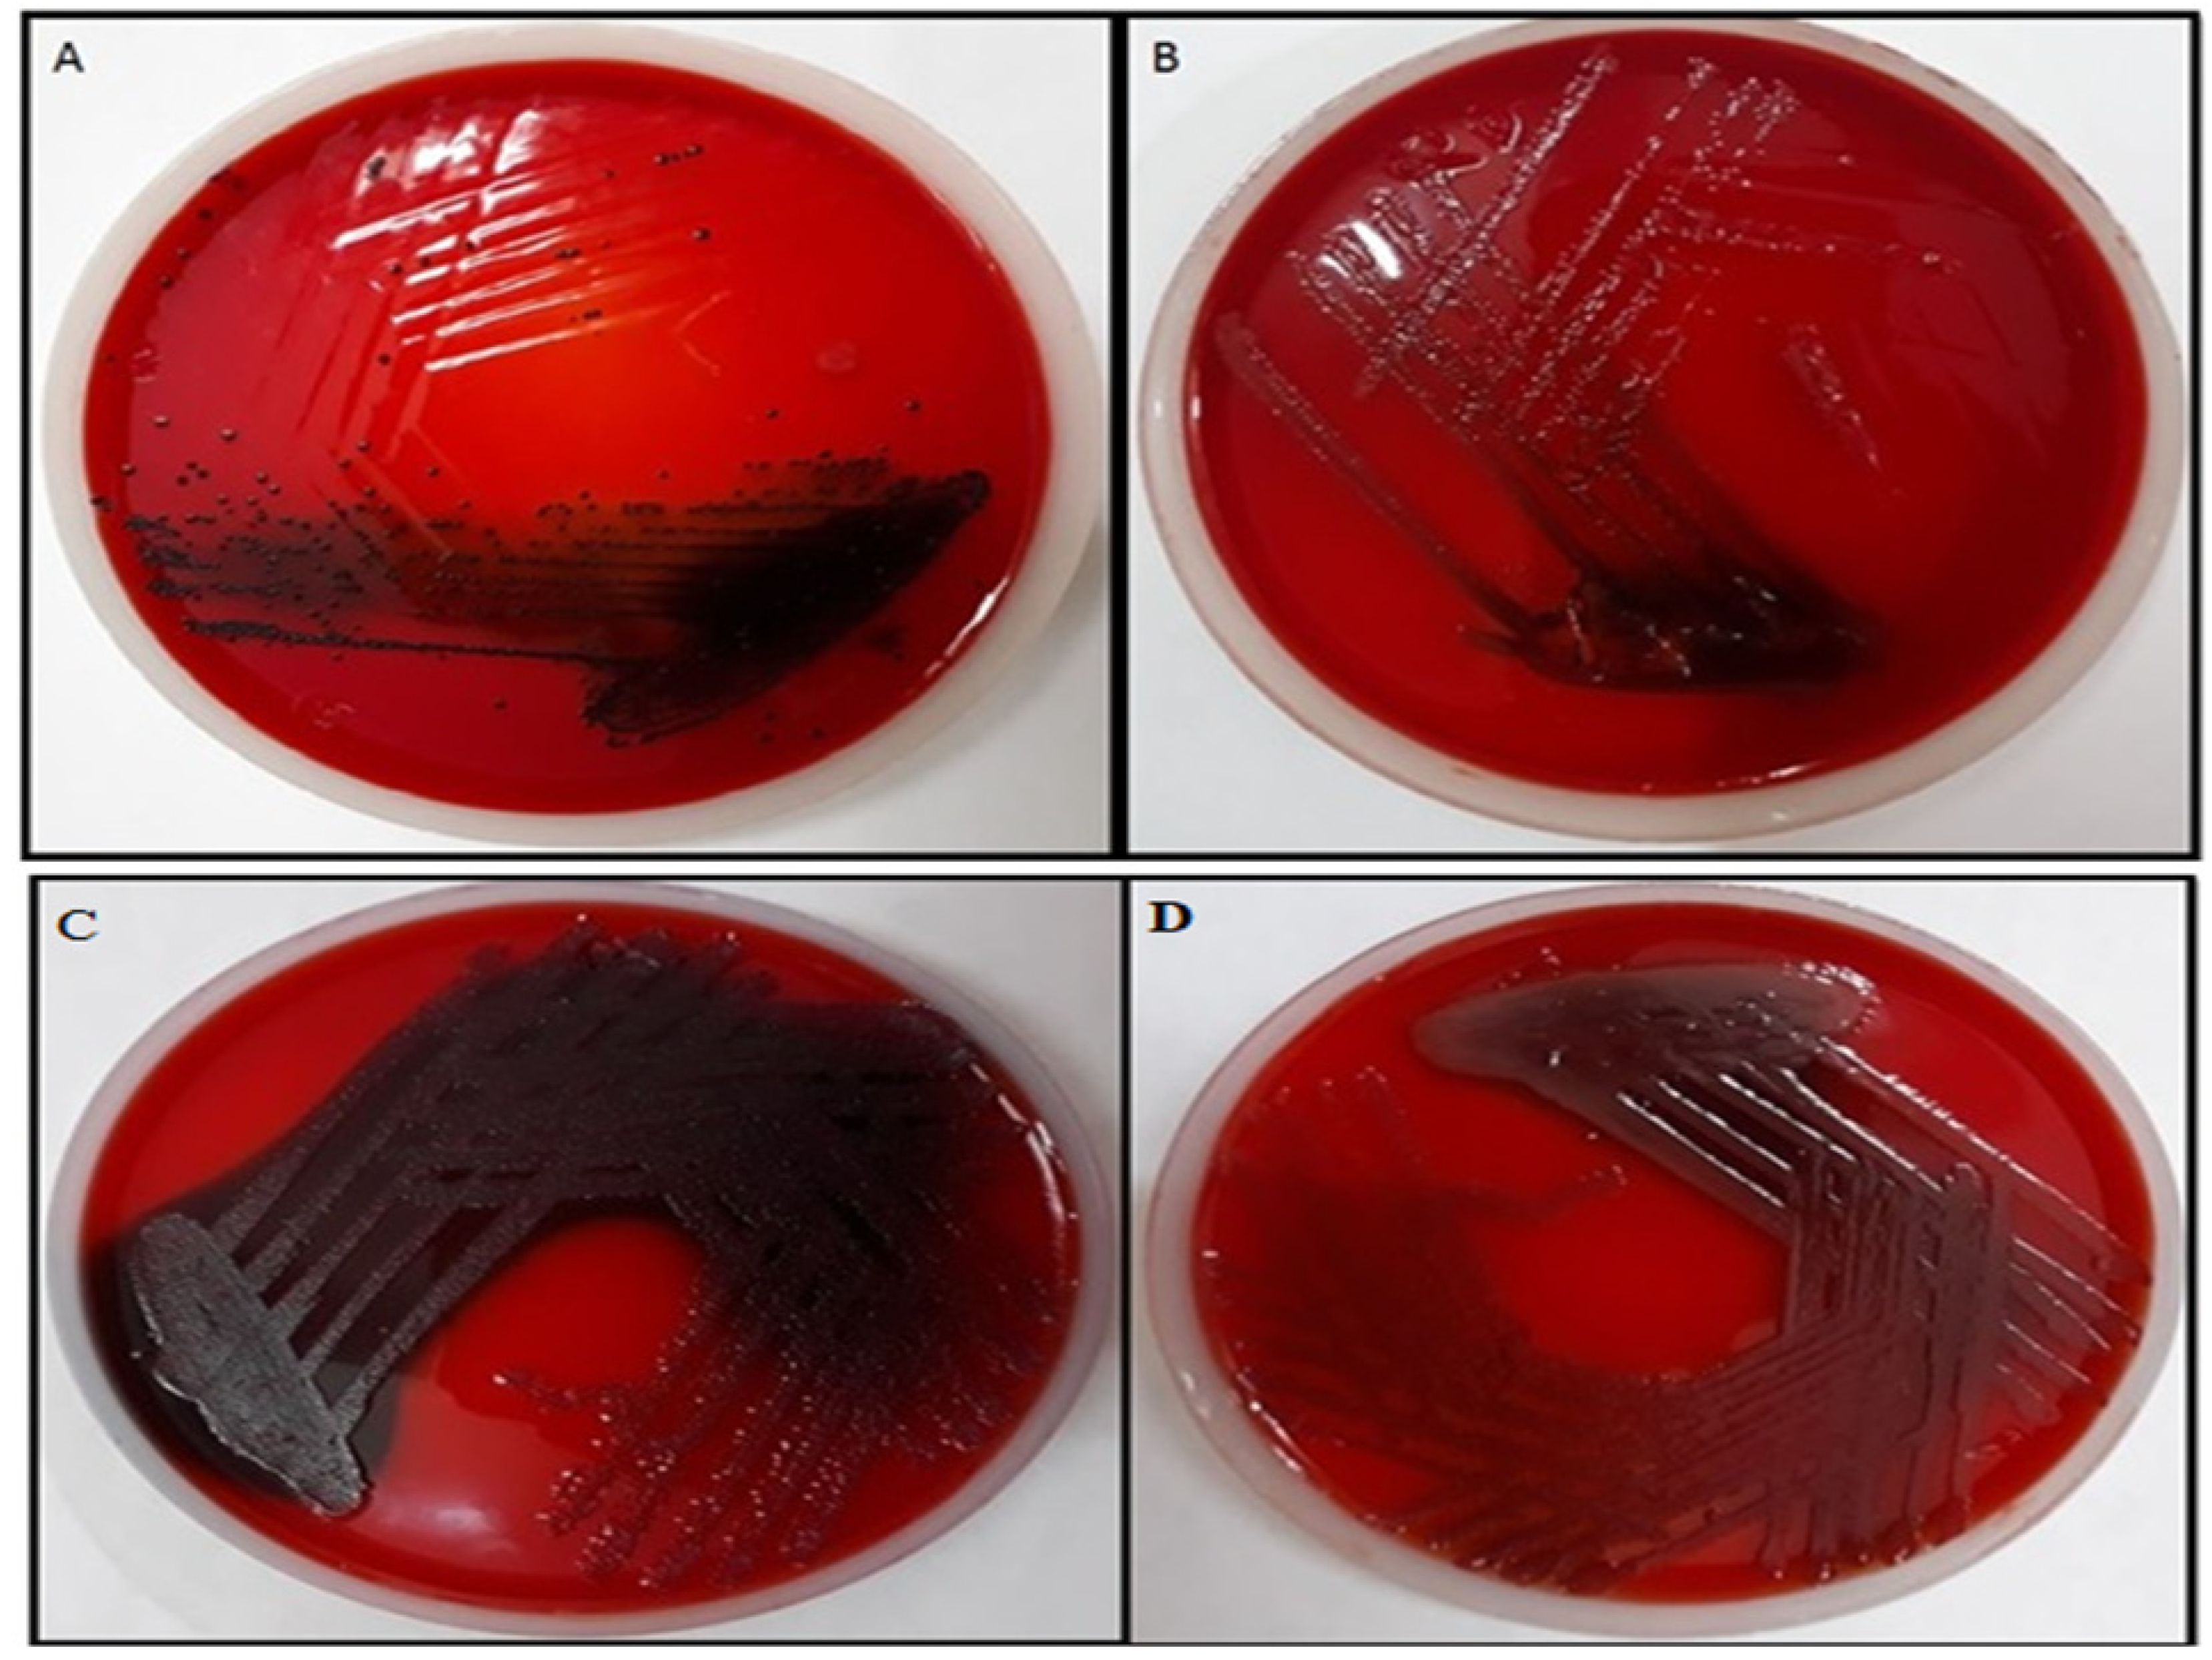
Molecules 27 08685 g011 Molecules 27 08685 g011

Biosynthesis of Gold Nanoparticles and Its Effect against Pseudomonas aeruginosa
Abstract
1. Introduction
2. Result
2.1. SEM, TEM, and XRD Analyses
2.2. GC-MS of Tinospora Cordifolia Stem Extract
2.3. Antibiotic Profile
2.4. MIC of TG-AuNPs
2.4.1. Effect of TG-AuNPs on Pyocyanin of P. aeruginosa
2.4.2. Effect of TG-AuNPs on Swarming and Swimming Motilities
2.4.3. Effect of TG-AuNPs on the Biofilm by Crystal Violet Assay
2.4.4. Effect of TG-AuNPs Using Congo Red Agar (CRA) Method
3. Discussion
4. Materials and Methods
4.1. Materials Used with Specification
- Stem of Tinospora cordifolia—for obtaining extract.
- Gold chloride (AuCl3), Sigma Aldrich (Germany)—salt for preparing gold nanoparticles.
- Methanol, Merck (Germany)—solvent used for extraction during GC-MS.
- Nutrient broth, Hi media (India)—liquid media for growth of bacteria.
- Nutrient agar, Hi media (India)—solid media for growth of bacteria.
- Chloroform, Merck (Germany)—used in pyocyanin extraction.
- Hydrochloric acid (HCl), Rankem (India)—used in pyocyanin extraction.
- Glucose, Rankem (India)—inoculated with nutrient media for swarming and swimming assay.
- Bacteriological agar, Hi media (India)—for solidifying liquid media.
- Crystal violet, Merck (Germany)—used in biofilm assay.
- Brain heart infusion, Hi media (India)—media used in Congo red biofilm assay.
- Sucrose, Rankem (India)—for analyzing biofilm using Congo red assay, since sucrose provides extra nutrients for growth of microorganisms.
- Congo red, Merck (Germany)—dye used in biofilm assay.
4.2. Synthesis of AuNPs
4.3. Characterization of Nanoparticles
4.3.1. Scanning Electron Microscopy (SEM)
4.3.2. Transmission Electron Microscopy (TEM)
4.3.3. X-ray Diffraction (XRD)
4.4. GC-MS for Bioactive Compounds in Plant Extract
4.5. Bacterial Isolates
4.6. Determination of Minimum Inhibitory Concentration (MIC)
4.6.1. Effect of TG-AuNPs on Pyocyanin
4.6.2. Effect of TG-AuNPs on the Swarming Motility
4.6.3. Effect of TG-AuNPs on Swimming Motility
4.7. Antibiofilm Potential of TG-AuNPs
4.7.1. Effect of TG-AuNPs Using Crystal Violet Assay
4.7.2. Effect of TG-AuNPs Using Congo Red Assay
5. Conclusions
Supplementary Materials
Author Contributions
Funding
Institutional Review Board Statement
Informed Consent Statement
Data Availability Statement
Acknowledgments
Conflicts of Interest
Sample Availability
References
- Founou, R.C.; Founou, L.L.; Essack, S.Y. Clinical and economic impact of antibiotic resistance in developing countries: A systematic review and meta-analysis. PLoS ONE 2017, 12, e0189621. [Google Scholar] [CrossRef] [PubMed]
- Tillotson, G.S.; Zinner, S.H. Burden of antimicrobial resistance in an era of decreasing susceptibility. Expert Rev. Anti-Infect. Ther. 2017, 15, 663–676. [Google Scholar] [CrossRef] [PubMed]
- Abadi, A.T.B.; Rizvanov, A.A.; Haertlé, T.; Blatt, N.L. World Health Organization report: Current crisis of antibiotic resistance. BioNanoScience 2019, 9, 778–788. [Google Scholar] [CrossRef]
- De Oliveira, D.M.; Forde, B.M.; Kidd, T.J.; Harris, P.N.; Schembri, M.A.; Beatson, S.A.; Paterson, D.L.; Walker, M.J. Antimicrobial resistance in ESKAPE pathogens. Clin. Microbiol. Rev. 2020, 33, e00181-19. [Google Scholar] [CrossRef]
- Ventola, C.L. The antibiotic resistance crisis: Part 1: Causes and threats. Pharm. Ther. 2015, 40, 277–283. [Google Scholar]
- Marston, H.D.; Dixon, D.M.; Knisely, J.M.; Palmore, T.N.; Fauci, A.S.J.J. Antimicrobial resistance. JAMA 2016, 316, 1193–1204. [Google Scholar] [CrossRef]
- Mizar, P.; Arya, R.; Kim, T.; Cha, S.; Ryu, K.-S.; Yeo, W.-S.; Bae, T.; Kim, D.W.; Park, K.H.; Kim, K.K.; et al. Total Synthesis of Xanthoangelol B and Its Various Fragments: Toward Inhibition of Virulence Factor Production of Staphylococcus aureus. J. Med. Chem. 2018, 61, 10473–10487. [Google Scholar] [CrossRef]
- Yeo, W.-S.; Arya, R.; Kim, K.K.; Jeong, H.; Cho, K.H.; Bae, T. The FDA-approved anti-cancer drugs, streptozotocin and floxuridine, reduce the virulence of Staphylococcus aureus. Sci. Rep. 2018, 8, 2521. [Google Scholar] [CrossRef]
- Imdad, S.; Chaurasia, A.K.; Kim, K.K. Identification and validation of an antivirulence agent targeting HlyU-regulated virulence in Vibrio vulnificus. Front. Cell Infect. Microbiol. 2018, 8, 152. [Google Scholar] [CrossRef]
- Rice, L.B. Federal Funding for the Study of Antimicrobial Resistance in Nosocomial Pathogens: No ESKAPE; The University of Chicago Press: Chicago, IL, USA, 2008; Volume 197, pp. 1079–1081. [Google Scholar]
- Tacconelli, E.; Magrini, N.; Kahlmeter, G.; Singh, N. Global Priority List of Antibiotic-Resistant Bacteria to Guide Research, Discovery, and Development of New Antibiotics; World Health Organization: Geneva, Switzerland, 2017; Volume 27, pp. 318–327. [Google Scholar]
- CDC. Antibiotic Resistance Threats in the United States; Department of Health and Human Services; CDC: Atlanta, GA, USA, 2019; pp. 1–150.
- Rajkowska, K.; Otlewska, A.; Guiamet, P.S.; Wrzosek, H.; Machnowski, W. Pre-Columbian Archeological Textiles: A Source of Pseudomonas aeruginosa with Virulence Attributes. Appl. Sci. 2020, 10, 116. [Google Scholar] [CrossRef]
- Britigan, B.E.; Roeder, T.L.; Rasmussen, G.T.; Shasby, D.M.; McCormick, M.L.; Cox, C.D. Interaction of the Pseudomonas aeruginosa secretory products pyocyanin and pyochelin generates hydroxyl radical and causes synergistic damage to endothelial cells. Implications for Pseudomonas-associated tissue injury. J. Clin. Investig. 1992, 90, 2187–2196. [Google Scholar] [CrossRef] [PubMed]
- Denning, G.M.; Wollenweber, L.A.; Railsback, M.A.; Cox, C.D.; Stoll, L.L.; Britigan, B.E. Pseudomonas pyocyanin increases interleukin-8 expression by human airway epithelial cells. Infect. Immun. 1998, 66, 5777–5784. [Google Scholar] [CrossRef] [PubMed]
- Lau, G.W.; Ran, H.; Kong, F.; Hassett, D.J.; Mavrodi, D. Pseudomonas aeruginosa pyocyanin is critical for lung infection in mice. Infect. Immun. 2004, 72, 4275–4278. [Google Scholar] [CrossRef] [PubMed]
- Behzadi, P.; Baráth, Z.; Gajdács, M. It’s Not Easy Being Green: A Narrative Review on the Microbiology, Virulence and Therapeutic Prospects of Multidrug-Resistant Pseudomonas aeruginosa. Antibiotics 2021, 10, 42. [Google Scholar] [CrossRef] [PubMed]
- Khan, F.; Pham, D.T.N.; Oloketuyi, S.F.; Kim, Y.-M. Regulation and controlling the motility properties of Pseudomonas aeruginosa. Appl. Microbiol. Biotechnol. 2020, 104, 33–49. [Google Scholar] [CrossRef] [PubMed]
- Khatoon, Z.; McTiernan, C.D.; Suuronen, E.J.; Mah, T.-F.; Alarcon, E.I. Bacterial Biofilm Formation on Implantable Devices and Approaches to its Treatment and Prevention. Heliyon 2018, 4, e01067. [Google Scholar] [CrossRef] [PubMed]
- Ramage, G.; Williams, C. The Clinical Importance of Fungal Biofilms. Adv. Appl. Microbiol. 2013, 84, 27–83. [Google Scholar] [CrossRef]
- Shakibaie, M.R. Bacterial Biofilm and its Clinical Implications. Ann. Microbiol. Res. 2018, 2, 45–50. [Google Scholar] [CrossRef]
- Flemming, H.-C.; Wingender, J.; Szewzyk, U.; Steinberg, P.; Rice, S.A.; Kjelleberg, S. Biofilms: An emergent form of bacterial life. Nat. Rev. Microbiol. 2016, 14, 563–575. [Google Scholar] [CrossRef]
- Yin, W.; Wang, Y.; Liu, L.; He, J. Biofilms: The Microbial “Protective Clothing” in Extreme Environments. Int. J. Mol. Sci. 2019, 20, 3423. [Google Scholar] [CrossRef]
- Huh, A.J.; Kwon, Y.J. “Nanoantibiotics”: A new paradigm for treating infectious diseases using nanomaterials in the antibiotics resistant era. J. Control. Release 2011, 156, 128–145. [Google Scholar] [CrossRef] [PubMed]
- Bhardwaj, V.; Kaushik, A. Biomedical Applications of Nanotechnology and Nanomaterials. Micromachines 2017, 8, 298. [Google Scholar] [CrossRef] [PubMed]
- Suriyakala, G.; Sathiyaraj, S.; Babujanarthanam, R.; Alarjani, K.M.; Hussein, D.S.; Rasheed, R.A.; Kanimozhi, K. Green Synthesis of Gold Nanoparticles Using Jatropha s Jacq. Flower Extract and Their Antibacterial Activity. J. King Saud. Univ. Sci. 2022, 34, 101830. [Google Scholar] [CrossRef]
- Botteon, C.E.A.; Silva, L.B.; Ccana-Ccapatinta, G.V.; Silva, T.S.; Ambrosio, S.R.; Veneziani, R.C.S.; Bastos, J.K.; Marcato, P.D. Biosynthesis and characterization of gold nanoparticles using Brazilian red propolis and evaluation of its antimicrobial and anticancer activities. Sci. Rep. 2021, 11, 1974. [Google Scholar] [CrossRef]
- Zainab; Saeed, K.; Ammara; Ahmad, S.; Ahmad, H.; Ullah, F.; Sadiq, A.; Uddin, A.; Khan, I.; Ahmad, M. Green Synthesis, Characterization and Cholinesterase Inhibitory Potential of Gold Nanoparticles. J. Mex. Chem. Soc. 2021, 65, 416–423. [Google Scholar]
- Ahmad, S.; Zainab; Ahmad, H.; Khan, I.; Alghamdi, S.; Almehmadi, M.; Ali, M.; Ullah, A.; Hussain, H.; Khan, N.M.; et al. Green synthesis of gold nanaoparticles using Delphinium Chitralense tuber extracts, their characterization and enzyme inhibitory potential. Braz. J. Biol. 2022, 82, e257622. [Google Scholar] [CrossRef] [PubMed]
- Tagad, C.K.; Dugasani, S.R.; Aiyer, R.; Park, S.; Kulkarni, A.; Sabharwal, S. Green Synthesis of Silver Nanoparticles and Their Application for the Development of Optical Fiber Based Hydrogen Peroxide Sensors. Sens. Actuators B Chem. 2013, 183, 144–149. [Google Scholar] [CrossRef]
- Abdel-Halim, E.S.; El-Rafie, M.H.; Al-Deyab, S.S. Polyacrylamide/Guar Gum Graft Copolymer for Preparation of Silver Nanoparticles. Carbohydr. Polym. 2011, 85, 692–697. [Google Scholar] [CrossRef]
- Parthipan, M.; Aravindhan, V.; Rajendran, A. Medico-botanical study of Yercaud hills in the eastern Ghats of Tamil Nadu, India. Anc. Sci Life. 2011, 30, 104–109. [Google Scholar]
- Sangeetha, M.K.; Raghavendran, H.R.B.; Gayathri, V.; Vasanthi, H.R. Tinospora cordifolia attenuates oxidative stress and distorted carbohydrate metabolism in experimentally induced type 2 diabetes in rats. J. Nat. Med. 2011, 65, 544–550. [Google Scholar] [CrossRef]
- Gupta, R.; Sharma, V. Ameliorative effects of Tinospora cordifolia root extract on histopathological and biochemical changes induced by aflatoxin-b (1) in mice kidney. Toxicol. Int. 2011, 18, 94–98. [Google Scholar] [PubMed]
- Ali, S.G.; Ansari, M.A.; Khan, H.M.; Jalal, M.; Mahdi, A.A.; Cameotra, S.S. Crataeva nurvala nanoparticles inhibit virulence factors and biofilm formation in clinical isolates of Pseudomonas aeruginosa. J. Basic Microbiol. 2017, 57, 193–203. [Google Scholar] [CrossRef] [PubMed]
- Ali, S.G.; Ansari, M.A.; Khan, H.M.; Jalal, M.; Mahdi, A.A.; Cameotra, S.S. Antibacterial and antibiofilm potential of green synthesized silver nanoparticles against imipenem resistant clinical isolates of P. aeruginosa. BionanoScience 2018, 8, 544–553. [Google Scholar] [CrossRef]
- Jalal, M.; Ansari, M.A.; Alzohairy, M.A.; Ali, S.G.; Khan, H.M.; Almatroudi, A.; Siddiqui, M.I. Anticandidal activity of biosynthesized silver nanoparticles: Effect on growth, cell morphology, and key virulence attributes of Candida species. Int. J. Nanomed. 2019, 14, 4667–4679. [Google Scholar] [CrossRef] [PubMed]
- Ali, S.G.; Ansari, M.A.; Jamal, Q.M.S.; Almatroudi, A.; Alzohairy, M.A.; Alomary, M.N.; Al-Warthan, A. Butea Monosperma Seed Extract Mediated Biosynthesis of ZnO NPs and Their Antibacterial, Antibiofilm and AntiQuorum Sensing Potentialities. Arab. J. Chem. 2021, 14, 103044. [Google Scholar] [CrossRef]
- Islam, R.; Sun, L.M.; Zhang, L.B. Biomedical Applications of Chinese Herb-Synthesized Silver Nanoparticles by Phytonanotechnology. Nanomaterials 2021, 11, 2757. [Google Scholar] [CrossRef]
- Hu, F.; Song, B.; Wang, X.; Bao, S.; Shang, S.; Lv, S.; Fan, B.; Zhan, R.; Li, J. Green rapid synthesis of Cu2O/Ag heterojunctions exerting synergistic antibiosis. Chin. Chem. Chem. Lett. 2022, 33, 308–313. [Google Scholar] [CrossRef]
- Ali, S.G.; Ansari, M.A.; Alzohairy, M.A.; Alomary, M.N.; AlYahya, S.; Jalal, M.; Khan, H.M.; Asiri, S.M.M.; Ahmad, W.; Mahdi, A.A.; et al. Biogenic gold nanoparticles as potent antibacterial and antibiofilm nano-antibiotics against Pseudomonas aeruginosa. Antibiotics 2020, 9, 100. [Google Scholar] [CrossRef]
- El Shafey, A.M. Green synthesis of metal and metal oxide nanoparticles from plant leaf extracts and their applications: A review. Green Process. Synth. 2020, 9, 304–339. [Google Scholar] [CrossRef]
- Ahmed, S.; Ahmad, M.; Swami, B.L.; Ikram, S. A review on plants extract mediated synthesis of silver nanoparticles for antimicrobial applications: A green expertise. J. Adv. Res. 2016, 7, 17–28. [Google Scholar] [CrossRef]
- Jayaseelan, S.; Ramaswamy, D.; Dharmaraj, S. Pyocyanin: Production, applications, challenges and new insights. World J. Microbiol. Biotechnol. 2014, 30, 1159–1168. [Google Scholar] [CrossRef]
- Elshaer, S.L.; Shaaban, M.I. Inhibition of quorum sensing and virulence factors of Pseudomonas aeruginosa by biologically synthesized gold and selenium nanoparticles. Antibiotics 2021, 10, 1461. [Google Scholar] [CrossRef] [PubMed]
- Donlan, R.M. Biofilms: Microbial life on surfaces. Emerg. Infect. Dis. 2002, 8, 881–890. [Google Scholar] [CrossRef]
- Harshey, R.M. Bacterial motility on a surface: Many ways to a common goal. Annu. Rev. Microbiol. 2003, 57, 249–273. [Google Scholar] [CrossRef] [PubMed]
- Rather, P.N. Swarmer cell differentiation in Proteus mirabilis. Environ. Microbiol. 2005, 7, 1065–1073. [Google Scholar] [CrossRef] [PubMed]
- Khan, F.; Manivasagan, P.; Lee, J.-W.; Pham, D.T.N.; Oh, J.; Kim, Y.-M. Fucoidan-stabilized gold nanoparticle-mediated biofilm inhibition, attenuation of virulence and motility properties in Pseudomonas aeruginosa PAO1. Mar. Drugs 2019, 17, 208. [Google Scholar] [CrossRef] [PubMed]
- Allesen-Holm, M.; Barken, K.B.; Yang, L.; Klausen, M.; Webb, J.S.; Kjelleberg, S.; Molin, S.; Givskov, M.; Tolker-Nielsen, T. A characterization of DNA release in Pseudomonas aeruginosa cultures and biofilms. Mol. Microbiol. 2006, 59, 1114–1128. [Google Scholar] [CrossRef]
- Ciofu, O.; Tolker-Nielsen, T. Tolerance and resistance of Pseudomonas aeruginosa biofilms to antimicrobial agents-How P. aeruginosa can escape antibiotics. Front. Microbiol. 2019, 10, 913. [Google Scholar] [CrossRef]
- Hall, C.W.; Mah, T.F. Molecular mechanisms of biofilm-based antibiotic resistance and tolerance in pathogenic bacteria. FEMS Microbiol. Rev. 2017, 41, 276–301. [Google Scholar] [CrossRef]
- Rajkumari, J.; Busi, S.; Vasu, A.C.; Reddy, P. Facile green synthesis of baicalein fabricated gold nanoparticles and their antibiofilm activity against Pseudomonas aeruginosa PAO1. Microb. Pathog. 2017, 107, 261–269. [Google Scholar] [CrossRef]
- Qais, F.A.; Ahmad, I.; Altaf, M.; Alotaibi, S.H. Biofabrication of Gold Nanoparticles Using Capsicum annuum Extract and Its Antiquorum Sensing and Antibiofilm Activity against Bacterial Pathogens. ACS Omega 2021, 6, 16670–16682. [Google Scholar] [CrossRef] [PubMed]
- Clinical Laboratory Standards Institute. Performance Standards for Antimicrobial Susceptibility Testing, 22nd ed.; Informational Supplement Document M100-S22; Clinical Laboratory Standards Institute: Wayne, PA, USA, 2012. [Google Scholar]
- Ansari, M.A.; Khan, H.M.; Alzohairy, M.A.; Jalal, M.; Ali, S.G.; Pal, R.; Musarrat, J. Green synthesis of Al2O3 nanoparticles and their bactericidal potential against clinical isolates of multi-drug resistant Pseudomonas aeruginosa. World J. Microbiol. Biotechnol. 2015, 31, 153–164. [Google Scholar] [CrossRef] [PubMed]
- Essar, D.W.; Eberly, L.; Hadero, A.; Crawford, I.P. Identification and characterization of genes for a second anthranilate synthase in Pseudomonas aeruginosa: Interchangeability of the two anthranilate synthases and evolutionary implications. J. Bacteriol. 1990, 172, 884–900. [Google Scholar] [CrossRef]
- Chelvam, K.K.; Chai, L.C.; Thong, K.L. Variations in motility and biofilm formation of Salmonella enterica serovar Typhi. Gut Pathog. 2014, 6, 2. [Google Scholar] [CrossRef]
- O’Toole, G.A.; Kolter, R. Initiation of biofilm formation in Pseudomonas fluorescens WCS365 proceedsvia multiple, convergent signalling pathways: A genetic analysis. Mol. Microbiol. 1998, 28, 449–461. [Google Scholar] [CrossRef]

| Peak | R. Time | Area | Area% | Name |
|---|---|---|---|---|
| 1 | 23.767 | 27437724 | 12.95 | 7-Tetradecenal, (Z)- |
| 2 | 21.652 | 23992314 | 11.32 | n-Hexadecanoic acid, methyl ester |
| 3 | 23.692 | 22020115 | 10.39 | 9,12-octadecadienoic acid (Z,Z)- |
| 4 | 32.034 | 12640436 | 5.97 | BENZENE, (2-ETHYL-4-METHYLE-1,3-PENTADIENYL)- |
| 5 | 31.137 | 8164505 | 3.85 | Pregna-5,16-dien-20-one, 3-(acetyloxy)-16-methyle-, (3.beta.) |
| 6 | 24.007 | 7197068 | 3.40 | Octadecanoic acid |
| 7 | 33.871 | 6441213 | 3.04 | Octacosanol |
| 8 | 38.278 | 6350228 | 3.00 | .gamma.-Sitosterol |
| 9 | 37.853 | 5967832 | 2.82 | 1,4-METHANOAZULENE, DECAHYDRO-4,8,8-TRIMET |
| 10 | 17.570 | 5954103 | 2.81 | Inositol, 1-deoxy- |
| Standard (N = 1) | Clinical Isolate (N = 10) | ||
|---|---|---|---|
| Isolate | MIC (μgmL−1) | Isolates | MIC (μgmL−1) |
| PAO1 | 1000 | 20% | 1000 |
| 50% | 1500 | ||
| 30% | 1800 | ||
Publisher’s Note: MDPI stays neutral with regard to jurisdictional claims in published maps and institutional affiliations. |
© 2022 by the authors. Licensee MDPI, Basel, Switzerland. This article is an open access article distributed under the terms and conditions of the Creative Commons Attribution (CC BY) license (https://creativecommons.org/licenses/by/4.0/).
Share and Cite
Ali, S.G.; Jalal, M.; Ahmad, H.; Umar, K.; Ahmad, A.; Alshammari, M.B.; Khan, H.M. Biosynthesis of Gold Nanoparticles and Its Effect against Pseudomonas aeruginosa. Molecules 2022, 27, 8685. https://doi.org/10.3390/molecules27248685
Ali SG, Jalal M, Ahmad H, Umar K, Ahmad A, Alshammari MB, Khan HM. Biosynthesis of Gold Nanoparticles and Its Effect against Pseudomonas aeruginosa. Molecules. 2022; 27(24):8685. https://doi.org/10.3390/molecules27248685
Chicago/Turabian StyleAli, Syed Ghazanfar, Mohammad Jalal, Hilal Ahmad, Khalid Umar, Akil Ahmad, Mohammed B. Alshammari, and Haris Manzoor Khan. 2022. "Biosynthesis of Gold Nanoparticles and Its Effect against Pseudomonas aeruginosa" Molecules 27, no. 24: 8685. https://doi.org/10.3390/molecules27248685
APA StyleAli, S. G., Jalal, M., Ahmad, H., Umar, K., Ahmad, A., Alshammari, M. B., & Khan, H. M. (2022). Biosynthesis of Gold Nanoparticles and Its Effect against Pseudomonas aeruginosa. Molecules, 27(24), 8685. https://doi.org/10.3390/molecules27248685

